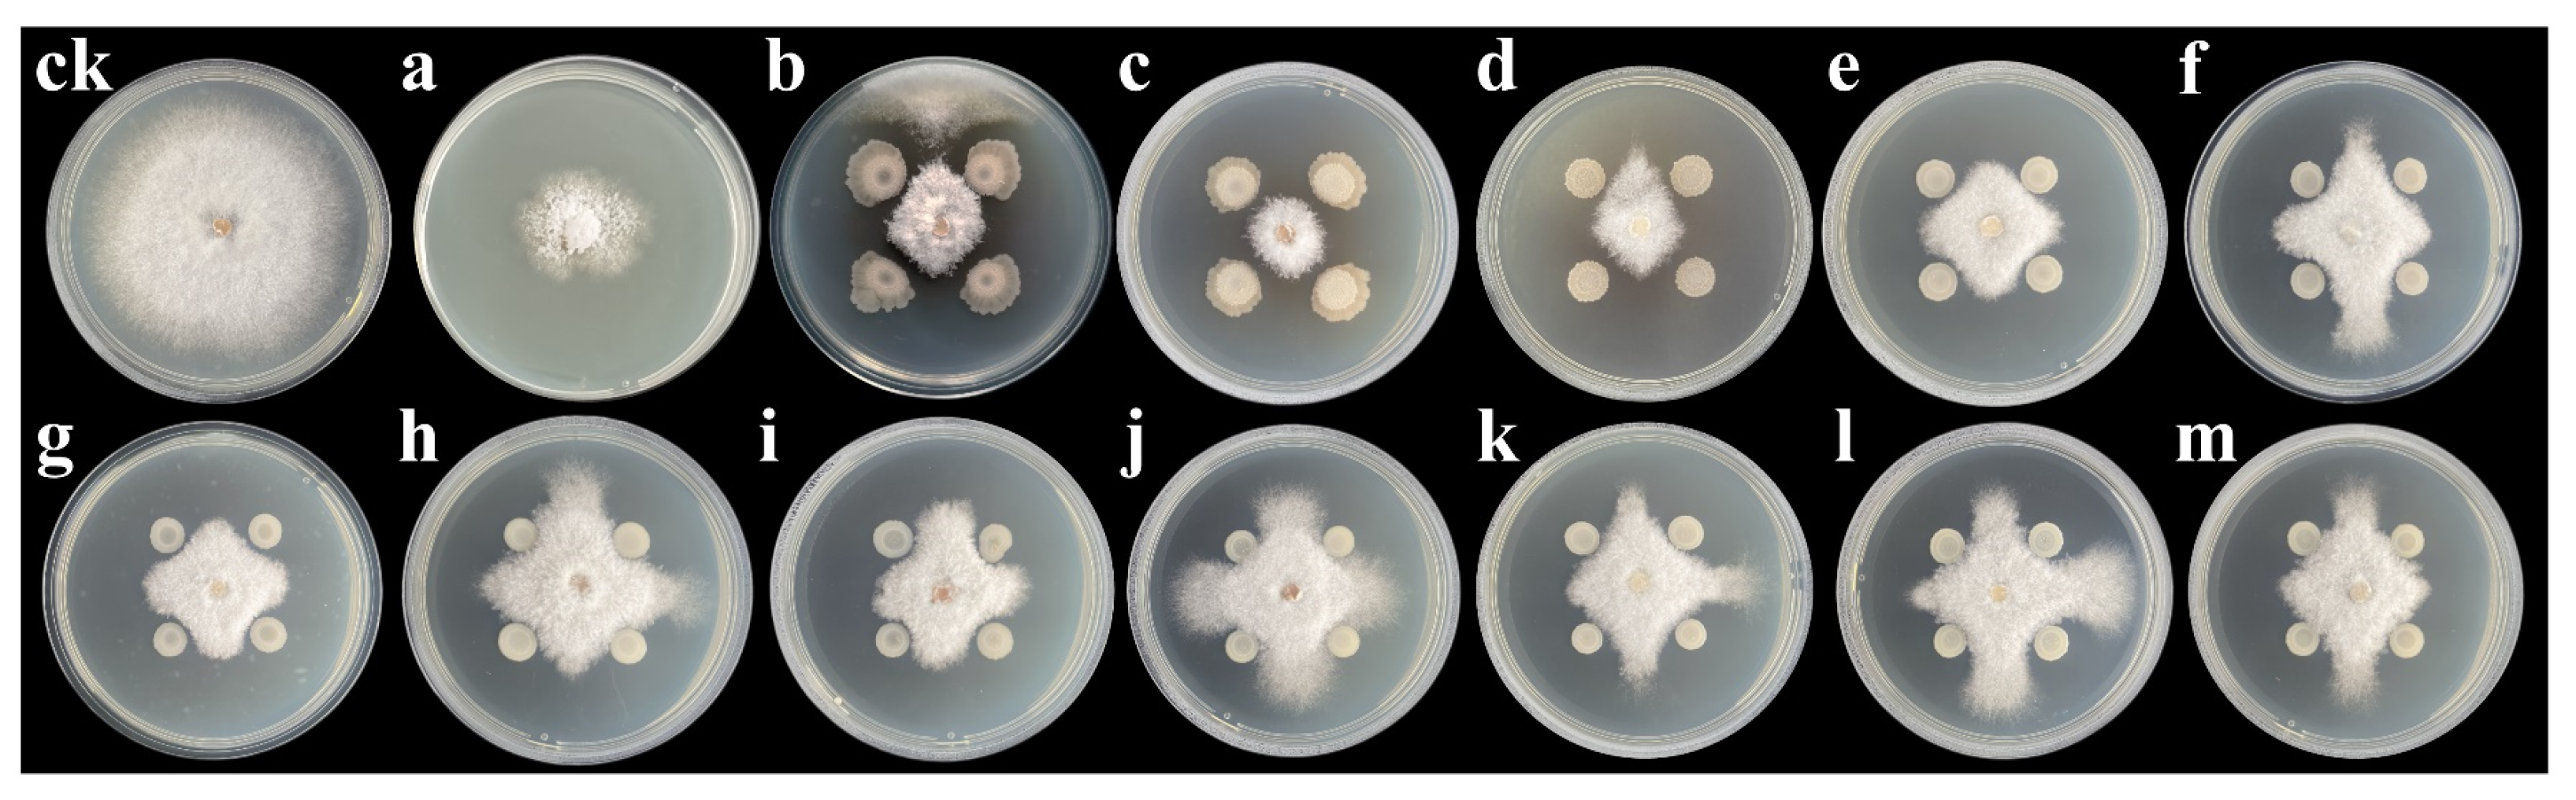
Jof 09 00132 g001 Jof 09 00132 g001

Plant Growth Promotion and Biocontrol of Leaf Blight Caused by Nigrospora sphaerica on Passion Fruit by Endophytic Bacillus subtilis Strain GUCC4
Abstract
1. Introduction
2. Materials and Methods
2.1. Sample Collection
2.2. Isolation of Endophytic Bacillus spp.
2.3. DNA Extraction, Amplification, and Sequencing
2.4. In Vitro Antagonism against N. Sphaerica
2.5. In Vitro Screening of Secondary Metabolites
2.6. Plant Growth Promotion Traits in the Greenhouse
2.7. Biological Control Traits against N. Sphaerica in the Greenhouse
2.8. Statistical Analysis
3. Results
3.1. Identification of Endophytic Bacteria and Screening of Their Antagonisms against N. sphaerica
3.2. Phylogenetic Analysis of Potential Bacillus Strains
3.3. Inhibitory Activity of Volatile Compounds and Culture Filtrates from Bacillus Strains against N. sphaerica
3.4. In Vitro Screening of Secondary Metabolites
3.5. Plant Growth Promoting Effect of Endophytic Bacillus Strains in Greenhouse
3.6. B. subtilis GUCC4 Biological Control of Leaf Blight in Greenhouse Experiment
4. Discussion
Author Contributions
Funding
Institutional Review Board Statement
Informed Consent Statement
Data Availability Statement
Acknowledgments
Conflicts of Interest
References
- Savary, S.; Willocquet, L.; Pethybridge, S.J.; Esker, P.; McRoberts, N.; Nelson, A. The global burden of pathogens and pests on major food crops. Nat. Ecol. Evol. 2019, 3, 430–439. [Google Scholar] [CrossRef] [PubMed]
- Tang, X.; Yangjing, G.; Zhuoma, G.; Guo, X.; Cao, P.; Yi, B.; Wang, W.; Ji, D.; Pasquali, M.; Baccelli, I.; et al. Biological characterization and in vitro fungicide screenings of a new causal agent of wheat Fusarium head blight in Tibet, China. Front. Microbiol. 2022, 13, 941734. [Google Scholar] [CrossRef] [PubMed]
- Bringel, F.; Couée, I. Plant-pesticide interactions and the global chloromethane budget. Trends Plant Sci. 2018, 23, 95–99. [Google Scholar] [CrossRef]
- Fones, H.N.; Bebber, D.P.; Chaloner, T.M.; Kay, W.T.; Steinberg, G.; Gurr, S.J. Threats to global food security from emerging fungal and oomycete crop pathogens. Nat. Food 2020, 1, 332–342. [Google Scholar] [CrossRef]
- Panseri, S.; Chiesa, L.; Ghisleni, G.; Marano, G.; Boracchi, P.; Ranghieri, V.; Malandra, R.M.; Roccabianca, P.; Tecilla, M. Persistent organic pollutants in fish: Biomonitoring and cocktail effect with implications for food safety. Food Addit. Contam. Part A 2019, 36, 601–611. [Google Scholar] [CrossRef] [PubMed]
- Joel, E.C. World Population in 2050: Assessing the Projections; Conference Series. [Proceedings]; Federal Reserve Bank of Boston: Boston, MA, USA, 1998; Volume 2001, p. 46. [Google Scholar]
- Chen, B.; Wu, D.; Zheng, H.; Li, G.; Cao, Y.; Chen, J.; Yan, F.; Song, X.; Lin, L. Complete genome sequence of Passiflora virus Y infecting passion fruit in China. Arch. Virol. 2021, 166, 1489–1493. [Google Scholar] [CrossRef]
- Naidu, R.; Biswas, B.; Willett, I.R.; Cribb, J.; Kumar Singh, B.; Paul Nathanail, C.; Coulon, F.; Semple, K.T.; Jones, K.C.; Barclay, A.; et al. Chemical pollution: A growing peril and potential catastrophic risk to humanity. Environ. Int. 2021, 156, 106616. [Google Scholar] [CrossRef] [PubMed]
- Lykogianni, M.; Bempelou, E.; Karamaouna, F.; Aliferis, K.A. Do pesticides promote or hinder sustainability in agriculture? The challenge of sustainable use of pesticides in modern agriculture. Sci. Total Environ. 2021, 795, 148625. [Google Scholar] [CrossRef] [PubMed]
- García-Giraldo, G.; Posada, L.F.; Pérez-Jaramillo, J.E.; Carrión, V.J.; Raaijmakers, J.M.; Villegas-Escobar, V. Bacillus subtilis EA-CB0575 inoculation of micropropagated banana plants suppresses black Sigatoka and induces changes in the root microbiome. Plant Soil 2022, 479, 513–527. [Google Scholar] [CrossRef]
- Xia, Z.; Huang, D.; Zhang, S.; Wang, W.; Ma, F.; Wu, B.; Xu, Y.; Xu, B.; Chen, D.; Zou, M.; et al. Chromosome-scale genome assembly provides insights into the evolution and flavor synthesis of passion fruit (Passiflora edulis Sims). Hortic. Res. 2021, 8, 14. [Google Scholar] [CrossRef]
- Shi, M.; Ali, M.M.; He, Y.; Ma, S.; Rizwan, H.M.; Yang, Q.; Li, B.; Lin, Z.; Chen, F. Flavonoids accumulation in fruit peel and expression profiling of related genes in purple (Passiflora edulis f. edulis) and yellow (Passiflora edulis f. flavicarpa) passion fruits. Plants 2021, 10, 2240. [Google Scholar] [CrossRef] [PubMed]
- Zhang, W.; Niu, X.L.; Yang, J.Y. First report of postharvest fruit rot on passion fruit (Passiflora edulis) caused by Lasiodiplodia theobromae in Mainland China. Plant Dis. 2021, 105, 1198. [Google Scholar] [CrossRef] [PubMed]
- Wang, Y.; Cernava, T.; Zhou, X.; Yang, L.; Baccelli, I.; Wang, J.; Gou, Y.; Sang, W.; Chen, X. First report of passion fruit leaf blight caused by Nigrospora sphaerica in China. Plant Dis. 2021, 106, 323. [Google Scholar] [CrossRef] [PubMed]
- Ismail, S.I.; Abd Razak, N.F. First report of Nigrospora sphaerica causing leaf spot on watermelon (Citrullus lanatus L.) in Malaysia. Plant Dis. 2020, 105, 488. [Google Scholar] [CrossRef]
- Hong, X.; Chen, S.; Wang, L.; Liu, B.; Yang, Y.; Tang, X.; Liu, Y.S.; Huang, S. First report of Nigrospora sphaerica causing fruit dried-shrink disease in Akebia trifoliata from China. Plant Dis. 2021, 105, 2244. [Google Scholar] [CrossRef]
- Rehman, A.; Alam, M.W.; Saira, M.; Naz, S.; Mushtaq, R.; Chohan, T.A.; Din, S.U.; Noureen, A.; Gilani, K.; Hussain, D. Nigrospora sphaerica causing leaf blight disease on Sesame in Pakistan. Plant Dis. 2022, 106, 317. [Google Scholar] [CrossRef]
- Hardoim, P.R.; Van Overbeek, L.S.; Berg, G.; Pirttilä, A.M.; Compant, S.; Campisano, A.; Döring, M.; Sessitsch, A. The hidden world within plants: Ecological and evolutionary considerations for defining functioning of microbial endophytes. Microbiol. Mol. Biol. Rev. 2015, 79, 293–320. [Google Scholar] [CrossRef]
- Harrison, J.G.; Griffin, E.A. The diversity and distribution of endophytes across biomes, plant phylogeny and host tissues: How far have we come and where do we go from here? Environ. Microbiol. 2020, 22, 2107–2123. [Google Scholar] [CrossRef]
- Santoyo, G.; Moreno-Hagelsieb, G.; Orozco-Mosqueda, M.; Glick, B.R. Plant growth-promoting bacterial endophytes. Microbiol. Res. 2016, 183, 92–99. [Google Scholar] [CrossRef]
- Strobel, G.A. Endophytes as sources of bioactive products. Microbes Infect. 2003, 5, 535–544. [Google Scholar] [CrossRef]
- Rosenblueth, M.; Martínez-Romero, E. Bacterial endophytes and their interactions with hosts. Mol. Plant-Microbe Interact. 2006, 19, 827–837. [Google Scholar] [CrossRef] [PubMed]
- Bulgarelli, D.; Schlaeppi, K.; Spaepen, S.; van Themaat, E.V.L.; Schulze-Lefert, P. Structure and functions of the bacterial microbiota of plants. Annu. Rev. Plant Biol. 2013, 64, 807–838. [Google Scholar] [CrossRef]
- Chen, X.; Pizzatti, C.; Bonaldi, M.; Saracchi, M.; Erlacher, A.; Kunova, A.; Berg, G.; Cortesi, P. Biological control of lettuce crop and host plant colonization by rhizospheric and endophytic streptomycetes. Front. Microbiol. 2016, 7, 714. [Google Scholar] [CrossRef]
- Carper, D.L.; Carrell, A.A.; Kueppers, L.M.; Frank, A.C. Bacterial endophyte communities in Pinus flexilis are structured by host age, tissue type, and environmental factors. Plant Soi. 2018, 428, 335–352. [Google Scholar] [CrossRef]
- Rani, S.; Kumar, P.; Dahiya, P.; Maheshwari, R.; Dang, A.S.; Suneja, P. Endophytism: A multidimensional approach to plant-prokaryotic microbe interaction. Front. Microbiol. 2022, 13, 861235. [Google Scholar] [CrossRef] [PubMed]
- Ma, Y.; Rajkumar, M.; Zhang, C.; Freitas, H. Beneficial role of bacterial endophytes in heavy metal phytoremediation. J. Environ. Manag. 2016, 174, 14–25. [Google Scholar] [CrossRef]
- Chen, L.; Shi, H.; Heng, J.; Wang, D.; Bian, K. Antimicrobial, plant growth-promoting and genomic properties of the peanut endophyte Bacillus velezensis LDO2. Microbiol. Res. 2019, 218, 41–48. [Google Scholar] [CrossRef]
- Rabbee, M.F.; Ali, M.S.; Choi, J.; Hwang, B.S.; Jeong, S.C.; Baek, K.H. Bacillus velezensis: A valuable member of bioactive molecules within plant microbiomes. Molecules 2019, 24, 1046. [Google Scholar] [CrossRef]
- Pacifico, M.G.; Eckstein, B.; Bettiol, W. Screening of Bacillus for the development of bioprotectants for the control of Fusarium oxysporum f. sp. vasinfectum and meloidogye incognita. Biol. Control 2021, 164, 104764. [Google Scholar] [CrossRef]
- Deng, Y.; Zhu, Y.; Wang, P.; Zhu, L.; Zheng, J.; Li, R.; Ruan, L.; Peng, D.; Sun, M. Complete genome sequence of Bacillus subtilis BSn5, an endophytic bacterium of Amorphophallus konjac with antimicrobial activity for the plant pathogen Erwinia carotovora subsp. carotovora. J. Bacteriol. 2011, 193, 2070–2071. [Google Scholar] [CrossRef]
- Aravind, R.; Kumar, A.; Eapen, S.J.; Ramana, K.V. Endophytic bacterial flora in root and stem tissues of black pepper (Piper nigrum L.) genotype: Isolation, identification and evaluation against Phytophthora capsici. Lett. Appl. Microbiol. 2009, 48, 58–64. [Google Scholar] [CrossRef]
- Jeong, H.; Choi, S.K.; Kloepper, J.W.; Ryu, C.M. Genome sequence of the plant endophyte Bacillus pumilus INR7, triggering induced systemic resistance in field crops. Genome Announc. 2014, 2, e01093-14. [Google Scholar] [CrossRef]
- Kloepper, J.W.; Reddy, M.S.; Rodríguez-Kabana, R.; Kenney, D.S.; Kokalis-Burelle, N.; Martinez-Ochoa, N. Application for rhizobacteria in transplant production and yield enhancement. Acta Hortic. 2004, 43, 217–230. [Google Scholar] [CrossRef]
- Kloepper, J.W.; Ryu, C.M. Bacterial endophytes as elicitors of induced systemic resistance. Microb. Root Endophytes 2006, 9, 33–52. [Google Scholar] [CrossRef]
- Afzal, I.; Shinwari, Z.K.; Sikandar, S.; Shahzad, S. Plant beneficial endophytic bacteria: Mechanisms, diversity, host range and genetic determinants. Microbiol. Res. 2019, 221, 36–49. [Google Scholar] [CrossRef]
- Li, Y.; Pan, J.; Zhang, R.; Wang, J.; Tian, D.; Niu, S. Environmental factors, bacterial interactions and plant traits jointly regulate epiphytic bacterial community composition of two alpine grassland species. Sci. Total Environ. 2022, 836, 155665. [Google Scholar] [CrossRef]
- Zuo, Y.; Hu, Q.; Liu, J.; He, X. Relationship of root dark septate endophytes and soil factors to plant species and seasonal variation in extremely arid desert in northwest China. Appl. Soil Ecol. 2022, 175, 104454. [Google Scholar] [CrossRef]
- Lane, D.J. 16S/23S rRNA Sequencing. Nucleic Acid Techniques in Bacterial Systematics; John Wiley and Sons: Chichester, UK, 1991; pp. 115–175. [Google Scholar]
- Yamamoto, S.; Harayama, S. PCR amplification and direct sequencing of gyrB genes with universal primers and their application to the detection and taxonomic analysis of Pseudomonas putida strains. Appl. Environ. Microbiol. 1995, 61, 1104–1109. [Google Scholar] [CrossRef]
- Rahman, M.A.; Begum, M.F.; Alam, M.F. Screening of Trichoderma isolates as a biological control agent against Ceratocystis paradoxa causing pineapple disease of sugarcane. Mycobiology 2009, 37, 277–285. [Google Scholar] [CrossRef]
- Xie, Z.L.; Li, M.; Wang, D.; Wang, F.; Shen, H.; Sun, G.; Feng, C.; Wang, X.; Chen, D.; Sun, X. Biocontrol efficacy of Bacillus siamensis LZ88 against brown spot disease of tobacco caused by Alternaria alternata. Biol. Control 2020, 1574, 104508. [Google Scholar] [CrossRef]
- Lau, E.T.; Tani, A.; Khew, C.Y.; Chua, Y.Q.; Hwang, S.S. Plant growth-promoting bacteria as potential bio-inoculants and biocontrol agents to promote black pepper plant cultivation. Microbiol. Res. 2020, 240, 126549. [Google Scholar] [CrossRef] [PubMed]
- Xu, W.; Wang, F.; Zhang, M.; Ou, T.; Wang, R.; Strobel, G.; Xie, J. Diversity of cultivable endophytic bacteria in mulberry and their potential for antimicrobial and plant growth-promoting activities. Microbiol. Res. 2019, 229, 126328. [Google Scholar] [CrossRef]
- Marten, P.; Smalla, K.; Berg, G. Genotypic and phenotypic differentiation of an antifungal biocontrol strain belonging to Bacillus subtilis. J. Appl. Microbiol. 2000, 89, 463–471. [Google Scholar] [CrossRef] [PubMed]
- Wu, Q. Turfgrass Diseases Survey in Dalian and Phytopathological Studies on Nigrospora Blight. Master’s Thesis, Jilin Agricultural University, Changchun, China, 2008. [Google Scholar] [CrossRef]
- Masmoudi, F.; Tounsi, S.; Dunlap, C.A.; Trigui, M. Halotolerant Bacillus spizizenii FMH45 promoting growth, physiological, and antioxidant parameters of tomato plants exposed to salt stress. Plant Cell Rep. 2021, 40, 1199–1213. [Google Scholar] [CrossRef]
- Wang, Y.; Liang, C.; Meng, Z.; Li, Y.; Abid, M.A.; Askari, M.; Wang, P.; Wang, Y.; Sun, G.; Cai, Y.; et al. Leveraging Aatriplex hortensis choline monooxygenase to improve chilling tolerance in cotton. Environ. Exp. Bot. 2019, 162, 364–373. [Google Scholar] [CrossRef]
- Blainski, J.M.L.; da Rocha Neto, A.C.; Schimidt, E.C.; Voltolini, J.A.; Rossi, M.J.; Di Piero, R.M. Exopolysaccharides from Lactobacillus plantarum induce biochemical and physiological alterations in tomato plant against bacterial spot. Appl. Microbiol. Biotechnol. 2018, 102, 4741–4753. [Google Scholar] [CrossRef]
- Gadioli, I.L.; da Cunha, M.S.B.; de Carvalho, M.V.O.; Costa, A.M.; Pineli, L.L.O. A systematic review on phenolic compounds in Passiflora plants: Exploring biodiversity for food, nutrition, and popular medicine. Crit. Rev. Food Sci. Nutr. 2018, 58, 785–807. [Google Scholar] [CrossRef]
- Liu, S.; Li, A.; Chen, C.; Guojun, C.; Limin, Z.; Guo, C.; Xu, M. De novo transcriptome sequencing in Passiflora edulis Sims to identify genes and signaling pathways involved in cold tolerance. Forests 2017, 8, 435. [Google Scholar] [CrossRef]
- Wu, Q.; Peng, X.; Yang, M.; Zhang, W.; Dazzo, F.B.; Uphoff, N.; Jing, Y.; Shen, S. Rhizobia promote the growth of rice shoots by targeting cell signaling, division and expansion. Plant Mol. Biol. 2018, 97, 507–523. [Google Scholar] [CrossRef]
- Gaiero, J.R.; McCall, C.A.; Thompson, K.A.; Day, N.J.; Best, A.S.; Dunfield, K.E. Inside the root microbiome: Bacterial root endophytes and plant growth promotion. Am. J. Bot. 2013, 100, 1738–1750. [Google Scholar] [CrossRef]
- Raza, W.; Wang, J.; Wu, Y.; Ling, N.; Wei, Z.; Huang, Q.; Shen, Q. Effects of volatile organic compounds produced by Bacillus amyloliquefaciens on the growth and virulence traits of tomato bacterial wilt pathogen Ralstonia solanacearum. Appl. Microbiol. Biotechnol. 2016, 100, 7639–7650. [Google Scholar] [CrossRef]
- Méndez-Bravo, A.; Cortazar-Murillo, E.M.; Guevara-Avendaño, E.; Ceballos-Luna, O.; Rodríguez-Haas, B.; Kiel-Martínez, A.L.; Hernández-Cristóbal, O.; Guerrero-Analco, J.A.; Reverchon, F. Plant growth-promoting rhizobacteria associated with avocado display antagonistic activity against Phytophthora cinnamomi through volatile emissions. PLoS ONE 2018, 13, e0194665. [Google Scholar] [CrossRef]
- Kai, M. Diversity and distribution of volatile secondary metabolites throughout Bacillus subtilis isolates. Front. Microbiol. 2020, 11, 559. [Google Scholar] [CrossRef]
- Vassilev, N.; Vassileva, M.; Nikolaeva, I. Simultaneous p-solubilizing and biocontrol activity of microorganisms: Potentials and future trends. Appl. Microbiol. Biotechnol. 2006, 71, 137–144. [Google Scholar] [CrossRef]
- Yasmin, S.; Hafeez, F.Y.; Mirza, M.S.; Rasul, M.; Arshad, H.M.I.; Zubair, M.; Iqbal, M. Biocontrol of bacterial leaf blight of rice and profiling of secondary metabolites produced by rhizospheric Pseudomonas aeruginosa BRp3. Front. Microbiol. 2017, 8, 1895. [Google Scholar] [CrossRef]
- Yasmin, S.; Zaka, A.; Imran, A.; Zahid, M.A.; Yousaf, S.; Rasul, G.; Arif, M.; Mirza, M.S. Plant growth promotion and suppression of bacterial leaf blight in rice by inoculated bacteria. PLoS ONE 2016, 11, e0160688. [Google Scholar] [CrossRef]
- Gandhi Pragash, M.; Narayanan, K.B.; Naik, P.R.; Sakthivel, N. Characterization of chryseobacterium aquaticum strain PUPC1 producing a novel antifungal protease from rice rhizosphere soil. J. Microbiol. Biotechnol. 2009, 19, 99–107. [Google Scholar] [CrossRef]
- Hashem, A.; Abd Allah, E.F.; Alqarawi, A.A.; Al-Huqail, A.A.; Shah, M.A. Induction of osmoregulation and modulation of salt stress in Acacia gerrardii benth. by arbuscular mycorrhizal fungi and Bacillus subtilis (BERA 71). BioMed Res. Int. 2016, 2016, 6294098. [Google Scholar] [CrossRef]
- Paz, I.C.; Santin, R.C.; Guimarães, A.M.; Rosa, O.P.; Dias, A.C.; Quecine, M.C.; Azevedo, J.L.; Matsumura, A.T. Eucalyptus growth promotion by endophytic Bacillus spp. Genet. Mol. Res. 2012, 11, 3711–3720. [Google Scholar] [CrossRef]
- Bolivar-Anillo, H.J.; González-Rodríguez, V.E.; Cantoral, J.M.; García-Sánchez, D.; Collado, I.G.; Garrido, C. Endophytic bacteria Bacillus subtilis, isolated from Zea mays, as potential biocontrol agent against Botrytis cinerea. Biology 2021, 10, 492. [Google Scholar] [CrossRef]
- Jessberger, N.; Dietrich, R.; Granum, P.E.; Märtlbauer, E. The Bacillus cereus food infection as multifactorial process. Toxins 2020, 12, 701. [Google Scholar] [CrossRef]
- Ahamed, N.A.; Panneerselvam, A.; Arif, I.A.; Abuthakir, M.H.S.; Jeyam, M.; Ambikapathy, V.; Mostafa, A.A. Identification of potential drug targets in human pathogen Bacillus cereus and insight for finding inhibitor through subtractive proteome and molecular docking studies. J. Infect. Public Health 2021, 14, 160–168. [Google Scholar] [CrossRef]
- Cormontagne, D.; Rigourd, V.; Vidic, J.; Rizzotto, F.; Bille, E.; Ramarao, N. Bacillus cereus induces severe infections in preterm neonates: Implication at the hospital and human milk bank level. Toxins 2021, 13, 123. [Google Scholar] [CrossRef]
- Abdallah, D.B.; Frikha-Gargouri, O.; Tounsi, S. Rizhospheric competence, plant growth promotion and biocontrol efficacy of Bacillus amyloliquefaciens subsp. plantarum strain 32a. Biol. Control 2018, 124, 61–67. [Google Scholar] [CrossRef]
- Rojas-Solis, D.; Vences-Guzmán, M.Á.; Sohlenkamp, C.; Santoyo, G. Antifungal and plant growth–promoting bacillus under saline stress modify their membrane composition. J. Soil Sci. Plant Nutr. 2020, 20, 1549–1559. [Google Scholar] [CrossRef]
- Kumar, A.; Verma, J.P. Does plant-microbe interaction confer stress tolerance in plants: A review? Microbiol. Res. 2018, 207, 41–52. [Google Scholar] [CrossRef]
- Gao, X.; Gong, Y.; Huo, Y.; Han, Q.; Kang, Z.; Huang, L. Endophytic Bacillus subtilis strain E1R-J is a promising biocontrol agent for wheat powdery mildew. BioMed Res. Int. 2015, 2015, 462645. [Google Scholar] [CrossRef]
- Hazarika, D.J.; Goswami, G.; Gautom, T.; Parveen, A.; Das, P.; Barooah, M.; Boro, R.C. Lipopeptide mediated biocontrol activity of endophytic Bacillus subtilis against fungal phytopathogens. BMC Microbiol. 2019, 19, 71. [Google Scholar] [CrossRef]
- Xie, D.; Cai, X.; Yang, C.; Xie, L.; Qin, G.; Zhang, M.; Huang, Y.; Gong, G.; Chang, X.; Chen, H. Studies on the control effect of Bacillus subtilis on wheat powdery mildew. Pest Manag. Sci. 2021, 77, 4375–4382. [Google Scholar] [CrossRef]
- Ahmad, Z.; Wu, J.; Chen, L.; Dong, W. Isolated Bacillus subtilis strain 330-2 and its antagonistic genes identified by the removing PCR. Sci. Rep. 2017, 7, 1777. [Google Scholar] [CrossRef]
- Ding, T.; Su, B.; Chen, X.; Xie, S.; Gu, S.; Wang, Q.; Huang, D.; Jiang, H. An endophytic bacterial strain isolated from Eucommia ulmoides inhibits southern corn leaf blight. Front. Microbiol. 2017, 8, 903. [Google Scholar] [CrossRef]
- Gachango, E.; Kirk, W.; Schafer, R.; Wharton, P. Evaluation and comparison of biocontrol and conventional fungicides for control of postharvest potato tuber diseases. Biol. Control 2012, 63, 115–120. [Google Scholar] [CrossRef]
- Bae, S.; Kim, S.G.; Kim, Y.H. Biocontrol characteristics of Bacillus Species in suppressing stem rot of grafted cactus caused by Bipolaris cactivora. Plant Pathol. J. 2013, 29, 42–51. [Google Scholar] [CrossRef]
- Milijašević-Marčić, S.; Stepanović, M.; Todorović, B.; Duduk, B.; Stepanović, J.; Rekanović, E.; Potočnik, I. Biological control of green mould on Agaricus bisporus by a native Bacillus subtilis strain from mushroom compost. Eur. J. Plant Pathol. 2017, 148, 509–519. [Google Scholar] [CrossRef]

| Endophytic Bacterial Isolate | Accession Number in NCBI Database (Number of Nucleotide) | Closely Related Type Strain | Tentative Endophytic Bacterial Designation | Sequence Similarity in NCBI (%) | Inhibition Rate (%) |
|---|---|---|---|---|---|
| GUCC1001 | OM004035 | CLY07 | B. cereus | 100 | 69.463 ± 0.012 a |
| GUCC2 | ON882051 | CLY07 | B. cereus | 100 | 68.743 ± 0.002 a |
| GUCC3 | ON882052 | JCM 2152 | B. cereus | 100 | 69.527 ± 0.001 a |
| GUCC4 | ON882053 | ATCC 6051 | B. subtilis | 100 | 71.163 ± 0.000 a |
| GUCC5 | ON882054 | ATCC14579 | B. cereus | 100 | 68.988 ± 0.002 a |
| GUCC6 | ON882055 | ATCC14579 | B. cereus | 100 | 67.550 ± 0.003 a |
| GUCC7 | ON882056 | JCM 2152 | B. cereus | 100 | 69.847 ± 0.007 a |
| GUCC8 | ON882057 | ATCC 6051 | B. subtilis | 100 | 75.353 ± 0.011 a |
| GUCC9 | ON882058 | JCM 2152 | B. cereus | 100 | 69.210 ± 0.002 a |
| GUCC10 | ON882059 | JCM 2152 | B. cereus | 100 | 69.043 ± 0.001 a |
| GUCC11 | ON882060 | JCM 2152 | B. cereus | 100 | 68.823 ± 0.003 a |
| GUCC1011 | OM319531 | Gvt-Sh-12 | B. cereus | 100 | 27.437 ± 0.040 e |
| GUCC1012 | OM319532 | ATCC 14579T.112 | B. cereus | 100 | 48.450 ± 0.030 b |
| GUCC1013 | OM319533 | 1910ICU267 | B. altitudinis | 100 | - |
| GUCC1014 | OM319534 | HYSJ134 | B. anthracis | 100 | 49.103 ± 0.037 b |
| GUCC1015 | OM319535 | MSM-S1 | Bacillus sp. | 95.84 | - |
| GUCC1016 | OM319536 | TS1 | B. cereus | 99.93 | 31.550 ± 0.061 cde |
| GUCC1017 | OM319537 | HYSJ134 | B. anthracis | 100 | 49.017 ± 0.037 b |
| GUCC1018 | OM319538 | MLS-3-7 | A. tumefaciens | 100 | - |
| GUCC1019 | OM319539 | ATCC 14579T.112 | B. cereus | 100 | - |
| GUCC1020 | OM319540 | NA161 | B. cereus | 100 | 37.707 ± 0.038 bcde |
| GUCC1021 | OM319541 | ER6 | B. wiedmannii | 100 | 47.507 ± 0.045 bc |
| GUCC1022 | OM319542 | NS26 | B. cereus | 100 | - |
| GUCC1023 | OM319543 | HYSJ134 | B. anthracis | 100 | - |
| GUCC1024 | OM319544 | XS 24-5 | B. cereus | 100 | - |
| GUCC1025 | OM319545 | D51 | Bacillus sp. | 100 | - |
| GUCC1026 | OM319546 | 2 | B. thuringiensis | 100 | 50.390 ± 0.212 b |
| GUCC1027 | OM319547 | NS25 | B. cereus | 100 | 25.537 ± 0.041 e |
| GUCC1028 | OM319548 | LXJ11 | B. cereus | 100 | - |
| GUCC1029 | OM319549 | MLS-1-10 | A. tumefaciens | 100 | - |
| GUCC1030 | OM319550 | XS 6-4 | B. cereus | 100 | - |
| GUCC1031 | OM319551 | DGT10 | Bacillus sp. | 100 | - |
| GUCC1032 | OM319552 | 4589 | B. cereus | 100 | 30.023 ± 0.035 de |
| GUCC1033 | OM319553 | K44 | B. cereus | 100 | 47.070 ± 0.033 bc |
| GUCC1034 | OM319554 | MP2B-4 | B. cereus | 100 | - |
| GUCC1035 | OM319555 | 2_T22 | B. thuringiensis | 100 | 25.897 ± 0.047 e |
| GUCC1036 | OM319556 | AM3 | B. cereus | 100 | 41.840 ± 0.037 bcde |
| GUCC1037 | OM319557 | FJAT-45863 | B. cereus | 99.93 | - |
| GUCC1038 | OM319558 | 41KF2bT.26 | B. altitudinis | 100 | - |
| GUCC1039 | OM319559 | Gvt-Sh-12 | B. cereus | 100 | - |
| GUCC1040 | OM319560 | PB4 | B. pumilus | 100 | 25.537 ± 0.041 e |
| GUCC1041 | OM319561 | EH20 | B. wiedmannii | 100 | 49.140 ± 0.036 b |
| HUCC1042 | OM319562 | LXJ74 | B. cereus | 100 | 25.537 ± 0.041 e |
| GUCC1043 | OM319563 | XS 24-5 | B. cereus | 100 | 45.430 ± 0.063 bcd |
| Strain | Amylase | Protease | Cellulase | Phosphate Solubilization | IAA(μg/mL) |
|---|---|---|---|---|---|
| B. cereus GUCC5 | + | + | + | − | 3.171 ± 0.073 b |
| B. cereus GUCC10 | + | + | + | − | 3.612 ± 0.048 b |
| B. cereus GUCC2 | + | + | + | − | 3.281 ± 0.048 b |
| B. subtilis GUCC8 | + | + | + | + | 5.044 ± 0.443 a |
| B. cereus GUCC6 | + | + | + | − | 3.446 ± 0.048 b |
| B. cereus GUCC11 | + | + | + | − | 2.278 ± 0.089 c |
| B. cereus GUCC7 | + | + | + | − | − |
| B. cereus GUCC1001 | + | + | + | − | 3.198 ± 0.048 b |
| B. cereus GUCC9 | + | + | + | − | 3.364 ± 0.126 b |
| B. cereus GUCC3 | + | + | + | − | 3.198 ± 0.095 b |
| B. subtilis GUCC4 | + | + | + | + | 3.529 ± 0.048 b |
| Treatment | Stems Width (mm) | Plant Height (cm) | Leaf Length (cm) | Fresh Weight (g) | Leaf Surface Area (cm2) | Dry Weight (g) |
|---|---|---|---|---|---|---|
| Control (CK) | 2.972 ± 0.179 d | 2.333 ± 0.882 g | 9.522 ± 0.140 e | 1.551 ± 0.067 e | 84.116 ± 3.629 de | 0.453 ± 0.040 d |
| B. cereus GUCC11 | 3.678 ± 0.119 bc | 10.167 ± 1.092 f | 10.222 ± 0.361 de | 1.855 ± 0.154 de | 72.617 ± 6.018 ef | 0.501 ± 0.008 bcd |
| B. cereus GUCC5 | 4.223 ± 0.209 a | 13.833 ± 1.481 de | 11.089 ± 0.439 bcd | 2.517 ± 0.169 ab | 89.859 ± 6.044 de | 0.567 ± 0.026 ab |
| B. cereus GUCC1001 | 3.593 ± 0.148 bc | 21.667 ± 3.283 bc | 10.533 ± 0.282 cde | 1.802 ± 0.106 de | 101.768 ± 2.356 bcd | 0.467 ± 0.013 cd |
| B. cereus GUCC7 | 3.613 ± 0.129 bc | 14.667 ± 1.856 de | 10.422 ± 0.171 cde | 1.791 ± 0.170 de | 61.912 ± 4.641 f | 0.434 ± 0.034 d |
| B. cereus GUCC10 | 3.428 ± 0.148 bcd | 15.000 ± 2.517 a | 13.089 ± 0.436 a | 2.662 ± 0.113 a | 158.159 ± 6.726 a | 0.585 ± 0.032 a |
| B. cereus GUCC2 | 3.568 ± 0.120 bc | 2.333 ± 0.333 g | 10.378 ± 0.503 cde | 2.022 ± 0.215 cde | 84.627 ± 8.160 de | 0.472 ± 0.031 cd |
| B. subtilis GUCC4 | 3.823 ± 0.122 ab | 16.500 ± 1.258 ab | 12.067 ± 0.269 ab | 2.539 ± 0.205 ab | 112.447 ± 9.084 bc | 0.549 ± 0.026 abc |
| B. cereus GUCC3 | 3.613 ± 0.183 bc | 12.500 ± 2.466 de | 12.122 ± 0.271 ab | 2.390 ± 0.156 abc | 116.924 ± 7.821 b | 0.541 ± 0.021 abc |
| B. subtilis GUCC8 | 3.690 ± 0.206 bc | 6.333 ± 1.856 fg | 10.967 ± 0.412 cd | 2.091 ± 0.163 bcd | 98.676 ± 8.282 bcd | 0.494 ± 0.020 bcd |
| B. cereus GUCC6 | 3.256 ± 0.217 cd | 5.667 ± 0.882 fg | 9.600 ± 0.463 e | 1.568 ± 0.157 e | 74.100 ± 7.419 ef | 0.479 ± 0.027 cd |
| B. cereus GUCC9 | 3.498 ± 0.119 bc | 16.667 ± 3.179 cd | 11.500 ± 0.293 bc | 1.933 ± 0.059 cde | 95.864 ± 3.001 cd | 0.490 ± 0.015 bcd |
| Treatment | Disease Incidence (%) | Protection (%) | Log-Rank Test |
|---|---|---|---|
| Inoculated control | 75.45 | / | / |
| B. subtilis GUCC4 | 42.76 | 43.33 | 0.000 *** |
| Mancozeb | 37.39 | 50.44 | 0.000 *** |
| B. subtilis NCD_2 | 52.72 | 30.12 | 0.002 ** |
Disclaimer/Publisher’s Note: The statements, opinions and data contained in all publications are solely those of the individual author(s) and contributor(s) and not of MDPI and/or the editor(s). MDPI and/or the editor(s) disclaim responsibility for any injury to people or property resulting from any ideas, methods, instructions or products referred to in the content. |
© 2023 by the authors. Licensee MDPI, Basel, Switzerland. This article is an open access article distributed under the terms and conditions of the Creative Commons Attribution (CC BY) license (https://creativecommons.org/licenses/by/4.0/).
Share and Cite
Wang, J.; Qin, S.; Fan, R.; Peng, Q.; Hu, X.; Yang, L.; Liu, Z.; Baccelli, I.; Migheli, Q.; Berg, G.; et al. Plant Growth Promotion and Biocontrol of Leaf Blight Caused by Nigrospora sphaerica on Passion Fruit by Endophytic Bacillus subtilis Strain GUCC4. J. Fungi 2023, 9, 132. https://doi.org/10.3390/jof9020132
Wang J, Qin S, Fan R, Peng Q, Hu X, Yang L, Liu Z, Baccelli I, Migheli Q, Berg G, et al. Plant Growth Promotion and Biocontrol of Leaf Blight Caused by Nigrospora sphaerica on Passion Fruit by Endophytic Bacillus subtilis Strain GUCC4. Journal of Fungi. 2023; 9(2):132. https://doi.org/10.3390/jof9020132
Chicago/Turabian StyleWang, Junrong, Shun Qin, Ruidong Fan, Qiang Peng, Xiaojing Hu, Liu Yang, Zengliang Liu, Ivan Baccelli, Quirico Migheli, Gabriele Berg, and et al. 2023. "Plant Growth Promotion and Biocontrol of Leaf Blight Caused by Nigrospora sphaerica on Passion Fruit by Endophytic Bacillus subtilis Strain GUCC4" Journal of Fungi 9, no. 2: 132. https://doi.org/10.3390/jof9020132
APA StyleWang, J., Qin, S., Fan, R., Peng, Q., Hu, X., Yang, L., Liu, Z., Baccelli, I., Migheli, Q., Berg, G., Chen, X., & Cernava, T. (2023). Plant Growth Promotion and Biocontrol of Leaf Blight Caused by Nigrospora sphaerica on Passion Fruit by Endophytic Bacillus subtilis Strain GUCC4. Journal of Fungi, 9(2), 132. https://doi.org/10.3390/jof9020132

